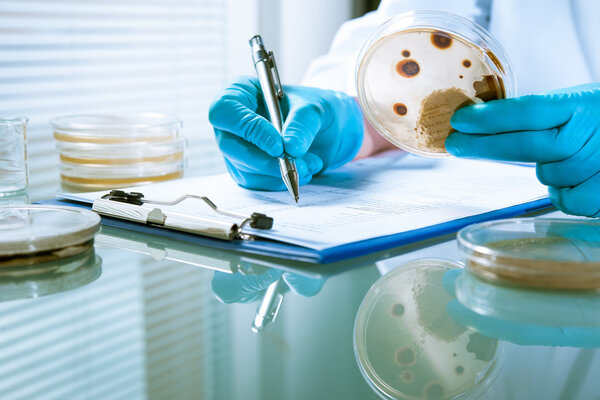
Agar plate with growing germs
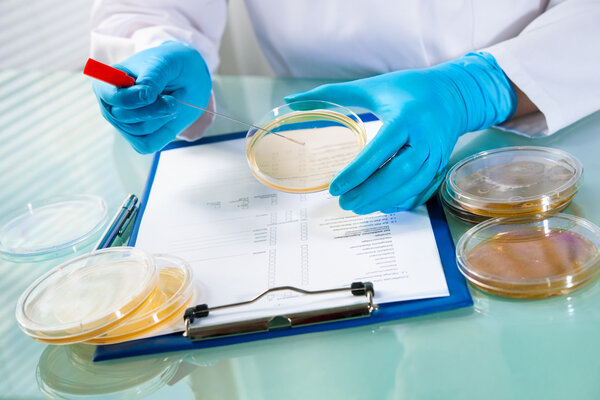
Agar plate with growing germs
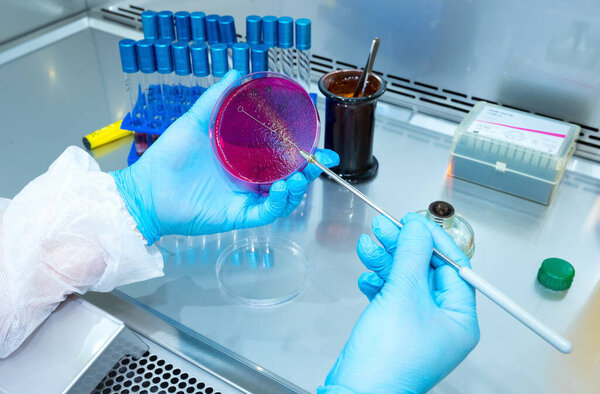
Hand holds a Petri dish with bacteria culture in the laboratory

- /
- Search /
- Agar plate with growing germs
Agar plate with growing germs
Germs growing on an agar plate in laboratory
image
image
Jan.29, 2015 16:22:32
24.39
0.67
333x500
667x1000
1333x2000
4032x6048
4032x6048
717
108
alexraths
GROWTH RISK HEALTH DANGER PLATE MEDICINE MEDICAL DISH HAZARD TECHNOLOGY HAND TOXIC CELL TEST HYGIENE DISEASE CULTURE BIOLOGY EXPERIMENT LAB LABORATORY SCIENCE SAFETY DISCOVERY MEDIA BACTERIUM RESEARCH GLOVE ANALYSIS SCIENTIFIC DRUGS MICROORGANISM ORGANISM FUNGI CONTAMINATION EXAMINATION BIOTECHNOLOGY BACTERIA SICKNESS MICROBIOLOGY SANITATION GERMS INSPECTION COLONIES EXPERIMENTAL PETRI AGAR BACTERIOLOGY MICROBIAL LISTERIA